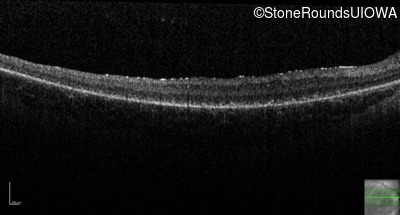
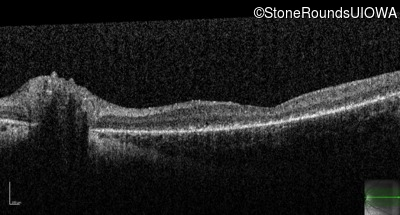
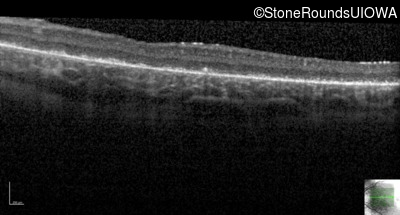
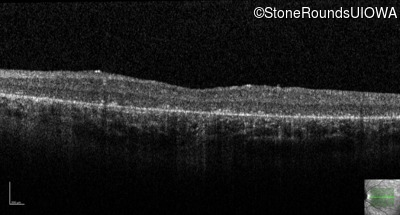
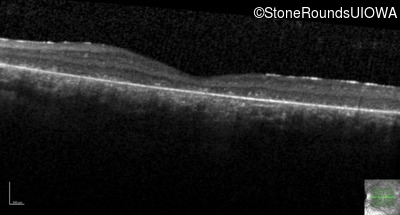
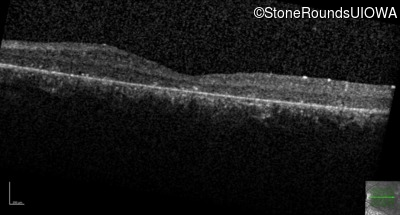
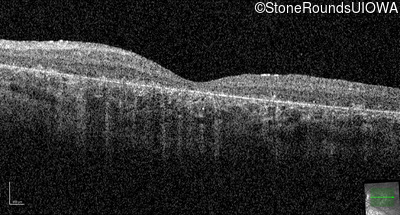
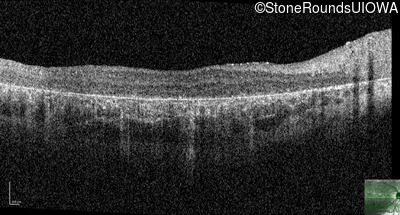
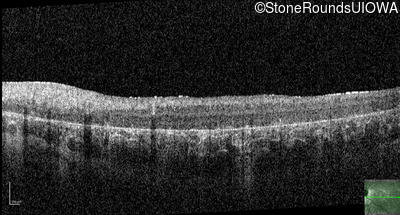
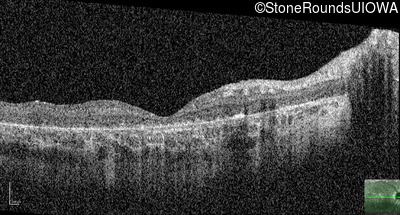
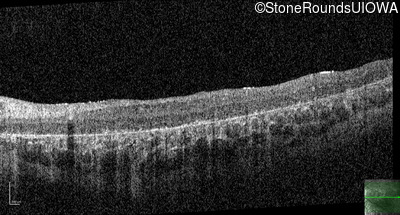

Case
SR275
Student Mode
AR Stargardt Disease (IIA)
Female
Female
Hidden
SR275
Student Mode
AR Stargardt Disease (IIA)
Female
Female
History
This 8 year old girl had normal vision until age 6 when she failed a school vision screening. That year, she was able to play softball well, but this year she often loses sight of the ball and is often hit by it.
| Age at visit: 8 years |
| OD | |||
|---|---|---|---|
| Age at visit: 11 years |
| Age at visit: 13 years |
| Age at visit: 14 years |
| Age at visit: 15 years |
| Age at visit: 16 years |
| Age at visit: 17 years |
| Age at visit: 18 years |
Diagnosis & molecular findings
| Disease | Gene | Allele 1 variant(s) | Allele 2 variant(s) | Inheritance mode |
|---|---|---|---|---|
| AR Stargardt Disease | ABCA4 | IVS38-10T>C | IVS38-10T>C | AR |
Disease:
Gene:
Allele 1:
IVS38-10T>C
Allele 2:
IVS38-10T>C
Inheritance:
AR